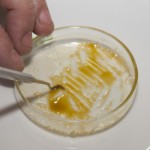
/forum/uploads/images/1383/1383974937.jpg

[ Huile (BHO, wax, Rosin) ]
Comment faire de l’huile de cannabis (BHO)

- filousky

Modérateur
- 09 novembre 2013 à 06:29

Huile de cannabis, BHO.
La première personne qui introduisit l’huile de cannabis en Angleterre fut le Dr. O’Shaughnessy. C’était en 1840, et dès lors sa consommation s’étendit massivement au sein de la population jusqu’à atteindre le niveau actuel de l’aspirine dans notre société.
Dans cet article, nous allons nous intéresser à la populaire extraction de trichomes connue comme BHO (Butane Honey Oil), qui est actuellement très répandue dans la communauté cannabique internationale.
Le résultat est une huile ressemblant au miel, extrêmement concentrée, pouvant dépasser 70% de THC. Le procédé de fabrication est très simple et pourra facilement être réalisé à la maison, à condition d’être prudent. Pour ceci nous aurons besoin de quelques accessoires faciles à trouver.

Matériel nécessaire pour faire le BHO.
Matériel pour extraire l’huile de cannabis (BHO):
Extracteur de résine (ou petit tube de cuivre avec bouchon de 22mm en cuivre et valvule pour le gaz).
Gaz butane 0% impuretés: Gaz butane Colibri, Atomic, etc…
Filtre à café ou maille de 25 microns.
1 plat en pyrex.
Lames propres.
Scotch isolant ou brides.
Papier cuisson.
La quantité de cannabis dépendra de la taille du tube d’extraction. Il est important d’utiliser de la marijuana de grande qualité pour un résultat optimal.
Processus d’extraction de l’huile de cannabis (BHO):
Il existe différentes techniques pour obtenir du BHO, nous expliquerons ici une méthode simple et efficace, qui permettra d’extraire une résine de première qualité. Il est très important d’utiliser du gaz butane 0% d’impuretés, sur le plan sanitaire comme gustatif, ces impuretés pouvant subsister dans la matière finale. Pour cet exemple nous avons utilisé la variété de cannabis K13 Haze de Philosopher Seeds, cultivée en extérieur.

Insertion du cannabis
Nous commençons par introduire le cannabis dans l’extracteur de résine. L’herbe devra être préparée en parties homogènes, sans pour autant devoir la mouliner, on cassera simplement les plus grosses parties.
Il est important de ne pas laisser de poches d’air, car la quantité de résine extraite en serait alors grandement réduite. L’herbe doit être légèrement tassée, sans la compacter on s’assurera tout de même qu’il ne reste pas de trous d’air, afin que le gaz puisse imprégner tout le cannabis présent dans le tube.

Fixer la toile
Nous fixerons la maille à l’une des extrémités du tube, à l’aide de scotch résistant ou d’une bride (cela dépendra du tube que nous utiliserons) et de l’autre nous fixerons le couvercle avec l’adaptateur pour la valvule de gaz.
Nous pourrons placer le tube au congélateur quelques heures, car il sera plus facile d’extraire les trichomes sur de l’herbe congelée. Ensuite, nous pourrons faire passer le gaz à travers l’extracteur.
Selon la taille du tube et son diamètre, les quantités de butane à utiliser varieront. Maintenant nous nous préparons à recueillir le gaz dans le plat de pyrex.

Cannabinoïdes extraits au gaz
Il est très important de respecter certaines mesures de sécurité pendant ce protocole: ne pas fumer, s’éloigner de toute flamme ou étincelle possible, et réaliser idéalement l’extraction à l’extérieur pour éviter l’accumulation du gaz. Les vêtements synthétiques pouvant produire de l’électricité statique, comme les survêtements par exemple, sont à proscrire pour une sécurité maximale.
Après avoir introduit le gaz dans l’extracteur de résine, nous verrons après quelques secondes celui ci qui commencera à sortir par le bas du tube. Le gaz lorsqu’il entre en contact avec le pyrex s’évapore facilement. Il sera confortable d’utiliser des gants pour se protéger du froid intense produit par le gaz butane.
Nous pourrons observer le butane qui sortira sous forme liquide et de couleur dorée, de par son contenu en résine, nous arrêterons d’injecter du gaz lorsque le gaz sera de nouveau transparent, signe qu’il ne reste plus de glandes de résine à extraire.
Ajouter plus de gaz demanderait ensuite un travail plus long pour le faire s’évaporer puis le purger. Le changement de couleur du gaz, de doré à transparent, nous signale donc que la majorité de la résine est extraite.
Évaporation et purge de l’huile de cannabis (BHO):

Évaporation du BHO
Une fois les trichomes extraits, nous devrons éliminer le gaz restant en chauffant de l’eau dans une petite casserole, sur laquelle nous placerons un plat pour poser notre récipient d’huile (bain-marie), ce qui facilitera l’évaporation du gaz.
Ce processus peut prendre 1 heure, on remarquera la formation de petites bulles et, pour favoriser l’évaporation, nous pourrons les percer à l’aide d’une aiguille. Lorsqu’il n’en demeurera plus, nous pourrons récupérer le BHO avec des lames de rasoir.
Il est important que le plat de pyrex soit tiède pour retirer l’huile facilement. La température de travail doit toujours rester inférieure à 40° pour préserver les arômes du cannabis.
Passée une heure de travail nous disposerons de notre huile de cannabis.

Huile de marijuana
Nous laisserons alors refroidir l’huile avant de la chauffer de nouveau pendant une heure à la même température. Nous serons ainsi certains que tout le gaz soit éliminé.
La meilleure façon d’éliminer tout le gaz est d’utiliser une pompe à vide et un jeu de manomètres. Dans un prochain article nous expliquerons comment purger le BHO à l’aide d’une pompe à vide. Avec cette technique nous obtiendrons un autre type d’extraction nommé Budder, où l’huile se solidifie.
Une lame de rasoir permettra de récupérer l'huile de cannabis en toute facilité.

Récupération du BHO
Nous pouvons retirer le BHO avec les lames de rasoir, puis le placer quelques instants au congélateur pour décoller l’huile des lames avec facilité.
Étendre l'huile sur du papier cuisson augmentera la surface d'évaporation.
Purge manuelle de l’huile
Nous pourrons également utiliser du papier cuisson pour y étendre l’huile précédemment extraite, car celle ci n’y adhérera pas.
Ensuite nous placerons la feuille de papier et l’huile au congélateur pour qu’elle durcisse, il sera ensuite très facile de la décoller.
Le BHO est prêt à être conservé, on le placera dans un petit bocal en verre. La température de conservation de l’huile doit être basse, autour de 8ºC, pour qu’elle reste dure et facile à manipuler.
Détail d'huile de cannabis de type BHO.

Concentré de cannabis prêt à l'emploi.
Source : http://www.alchimiaweb.com/blogfr/comme … nabis-bho/
Hors ligne

- Speedbolls

Nouveau membre - 25 décembre 2013 à 15:12
Au début que j'ai pratiqué l' extraction au butane j'utisais les petites feuiles des buds bien trichomisé
dans un tube en avec environs 30g,cela donnais en effet de l'huile couleur miel bien bon mais
pas assez puissant et peu de quantité
Puis avec le poto on fait une bonne récolte et on sais permis de charger le tube en buds monstrueuseusent
thricomisé :langue:
lé resultat n'est plus de l'huile mais de la cire (wax) avec une production supérieure a 20% sur mon meillleur
coup pour 40g de buds = 8g de wax
Apres il faut extraire le gaz qui reste comme la dis filouski, moi je mets le pyrex sur une petite plancha
en position 2 pour commencer et au fur a mesure les bulles remontes ilreste plus qu'a toullier a l'aide d'un dabber et répéter cette opération sur 3,4 jours sans dépasser les 50° je m'aide avec avec un thermomètre
laser

Pour la consommation un bubbler reste le plus puissant et le mieux pour vaporiser ce produit hautement
concentré et l'atomiseur essenz adaptable sur e-cig un must

Dernière modification par Speedbolls (25 décembre 2013 à 15:14)
Le problème avec la drogue c'est quand il y a na plus.
Une journée sans rire et sans apprendre est une journée perdue.
Hors ligne

- Bootspoppers

Adhérent
- 04 août 2019 à 13:16
filousky a écrit
article, nous allons nous intéresser à la populaire extraction de trichomes connue comme BHO (Butane Honey Oil), qui est actuellement très répandue dans la communauté cannabique internationale.
Le résultat est une huile ressemblant au miel, extrêmement concentrée, pouvant dépasser 70% de THC. Le procédé de fabrication est très simple
Je decouvre ce produit a l'occasion d un fil sponsorisé sur instagram...
Je vais poster les photos. Le gars enduit ses pétards de cette huile...
Je me demande qu en penser...
Photo 1 : faire bouillir l huile
Photo 2:
Recueillir ce qu il appelle le miel
Photo 3 :resultat final après une semaine "d'épurage"
BHO
photo 4: le bho sur un petard comme decoration? Potentialisateur? 
Dernière modification par Bootspoppers (04 août 2019 à 19:32)
Hors ligne

- Bootspoppers

Adhérent
- 04 août 2019 à 19:30
Dernière modification par Bootspoppers (04 août 2019 à 19:32)
Hors ligne

- filousky

Modérateur
- 05 août 2019 à 13:04
Le BHO se consomme dans un vap-pen ou bien en "dabbing".
Bootspoppers a écrit
Photo 1 : faire bouillir l huile
Ce qui bout naturellement à température ambiante est le butane liquide. On a besoin de chauffer un peu que sur la fin de l'évaporation pour purger le BHO des dernière bulles de butane.
Amicalement
Fil
Dernière modification par filousky (05 août 2019 à 13:10)
Hors ligne
Sujets similaires dans les forums, psychowiki et QuizzZ
» [ Huile (BHO, wax, Rosin) ] Comment faire de l’huile de cannabis (BHO)
Affichage Bureau - A propos de Psychoactif - Politique de confidentialité - CGU - Contact -

 0, 2434 vues, dernier message :
0, 2434 vues, dernier message :  Soutenez PsychoACTIF
Soutenez PsychoACTIF